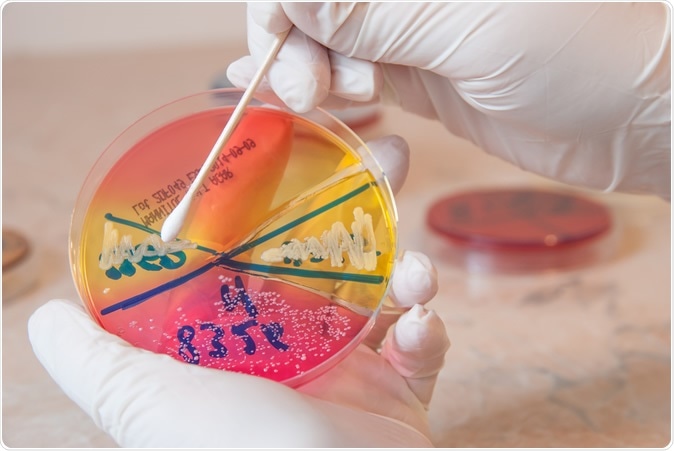
Sterile swab and Staphylococcus aureus bacteria on petri dish. Image Credit: Zaharia Bogdan Rares / Shutterstock

Antibiotic resistance is a big threat to global health, and a growing number of infections are now becoming harder to treat. Now, a team of researchers may have found a potent weapon against antibiotic-resistant bacteria, which can help treat persistent infections.
The researchers at the University of North Carolina Health Care developed a new way to make antibiotics more potent and able to kill disease-causing pathogens. Published in the journal Cell Chemical Biology, the study showed how the scientists formulated a way to make bacteria more vulnerable to some common antibiotics.
In the study, the researchers discovered that incorporating molecules dubbed as rhamnolipids can make certain antibiotics a hundred times more powerful against Staphylococcus aureus, which causes many infections that become persistent despite treatment.
Sterile swab and Staphylococcus aureus bacteria on petri dish. Image Credit: Zaharia Bogdan Rares / Shutterstock
The rhamnolipids successfully loosen up the outer membranes of the bacteria, making aminoglycoside molecules to enter easily and faster.
Antibiotic-resistant bacteria cases on the rise
Antibiotics are medicines used to prevent and treat bacterial infections. When the bacteria change in response to these drugs, they become antibiotic-resistant. They become very difficult to treat, and the number of cases is growing by the minute.
In 2013, the Centers for Disease Control and Prevention reported that at least 2 million people get an antibiotic-resistant infection each year in the United States. Of these, 23,000 people die.
One of the deadliest superbugs today is the Methicillin-resistant Staphylococcus aureus (MRSA), which is a resistant type of bacteria that commonly affects patients in health care settings wherein they acquire potentially life-threatening infections. In some cases, the patients get the infection in the community.
In the United States alone, about 80,461 people get infected with MRSA each year, and it kills about 11,285 people every year.

Staphylococcus aureus (MRSA). Illustration Credit: Tatiana Shepeleva / Shutterstock
Promising new technique to battle superbug infections
The new method could help many people against superbugs, which can cause serious complications if they’re left untreated. Also, it could help save many lives.
"There's a great need for new ways to kill bacteria that tolerate or resist standard antibiotics, and to that end we found that altering membrane permeability to induce aminoglycoside uptake is an extremely effective strategy against S. aureus," Dr. Brian Conlon, assistant professor in the department of microbiology and immunology at the UNC School of Medicine and study co-author, said.
The typical treatments for many Staphylococcus strains can’t kill the bacteria because of two factors – antibiotic resistance or less vulnerability. For instance, the bacterium can adapt its metabolism to make it possible to survive in low-oxygen areas, such as the mucus-filled lungs of people suffering from cystic fibrosis.
When this happens, the bacteria adapt to its environment, making the outer wall or membrane impermeable to aminoglycoside antibiotics, including tobramycin. But, in the study, the researchers found that rhamnolipids can enhance the potency of tobramycin against the bacteria.
In a series of experiments, they tested rhamnolipid-tobramycin combinations against Staphylococcus aureus that are difficult to eradicate via traditional methods. They discovered that rhamnolipids enhance tobramycin’s efficacy against Staphylococcus aureus, MRSA, tobramycin-resistant S. aureus strains from patients with cystic fibrosis, and some strains of S. aureus that have reduced susceptibility to antibiotics.
"Tobramycin doses that normally would have little or no effect on these S. aureus populations quickly killed them when combined with rhamnolipids." Lauren Radlinski, the co-author of the study, said.
Subsequently, they found that rhamnolipids can alter the membrane of the bacteria, making it permeable for the antibiotic to penetrate. The team tested several antibiotics, including tobramycin, amikacin, gentamicin, and kanamycin, which all had enhanced potency.
The efficacy and potency of the antibiotics were not only effective against S. aureus but also other species, such as Clostridiodes difficile, which is one of the fatal causes of diarrheal disease in hospitals.
"There's a huge number of bacterial interspecies interactions that could be influencing how well our antibiotics work," Radlinski explained.
"We aim to find them with the ultimate goal of improving the efficacy of current therapeutics and slowing the rise of antibiotic resistance,” she added.
Journal reference:
Chemical Induction of Aminoglycoside Uptake Overcomes Antibiotic Tolerance and Resistance in Staphylococcus aureus, Radlinski, Lauren C. et al.
Cell Chemical Biology. https://www.cell.com/cell-chemical-biology/fulltext/S2451-9456(19)30240-5